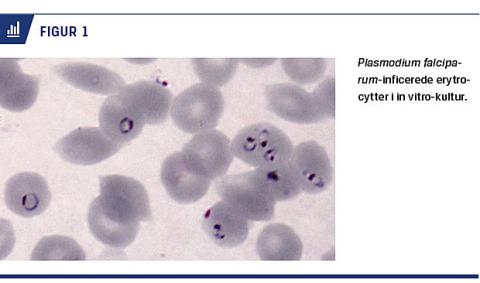

Malaria skyldes infektion med encellede blodparasitter af slægten Plasmodium. Parasitterne overføres, når en inficeret Anopheles-hunmyg med et stik injicerer parasitterne i blodbanen. Fem arter af malariaparasitter (P. falciparum, P. vivax, P. ovale, P. malariae og P. knowlesi) kan forårsage malaria hos mennesker. P. falciparum er årsag til den alvorligste sygdom og langt de fleste dødsfald. Hovedparten af sygdomsbyrden bæres af børn
under fem år og gravide kvinder i Afrika. Antallet af malariatilfælde og -dødsfald steg i slutningen af forrige århundrede, men siden årtusindeskiftet synes udviklingen at være vendt [1]. Der er imidlertid stor usikkerhed om størrelsen af det reelle fald i sygelighed og død og årsagerne hertil [2]. Det er sandsynligt, at øgede bevillinger til malariabekæmpelse, forøget udbredelse af imprægnerede myggenet, bedre adgang til effektive lægemidler, myggebekæmpelse og en generelt forbedret samfundsøkonomi i mange afrikanske lande indgår, men i hvor høj grad vides reelt ikke [2, 3].

Det er WHO’s ambition at have reduceret forekomsten af malaria med 90% i 2030, at have elimineret
malaria fra 35 lande, hvor sygdommen findes i dag, og at have forhindret dens reetablering i lande, der allerede i dag er malariafri [4]. Ud over usikkerheden om årsagerne til de senere års fald, er fortsatte fremskridt truet af stigende problemer med resistens mod alle de læge- og sprøjtemidler, der i dag bruges til forebyggelse og behandling [1]. En effektiv vaccine mod malaria ville være en potentielt afgørende forbedring af situationen, men der er fortsat kun en enkelt malariavaccine (RTS,S/AS01), der er så velafprøvet [5], at den står foran markedsføring [6]. Desværre giver RTS,S kun begrænset beskyttelse mod smitte og sygdom, dens effekt aftager hurtigt, og den selekterer muligvis for parasitvarianter, der ikke rammes af vaccinen [7, 8].
I Danmark er der 80-100 importerede malariatilfælde om året [9]. Til trods for de relativt få tilfælde, der importeres, har Danmark en lang tradition for at forske og deltage i bekæmpelsen af malaria. Vi beskriver her den danske indsats mod malaria gennem de seneste årtier og belyser nuværende forskningsområder.
HVAD FORSKES DER I?
Startskuddet til systematisk dansk malariaforskning blev WHO’s Tropical Disease Research Programme, som blev lanceret i 1975 med DANIDA som hoveddonor. Med programmet forsøgte man at afbøde den ulige globale fordeling af sundhedsforskningsmidler, hvor 90% af pengene blev brugt til forskning i sundhedsproblemer for de rigeste 10% af verdens befolkning, og 10% blev brugt til forskning i sundhedsproblemerne for de resterende 90%. DANIDA fulgte sit internationale engagement op med støtte til igangsættelse af dansk malariaforskning. Også Det Lægevidenskabelige Forskningsråd og EU’s internationale forskningsprogram støttede tidligt dansk malariaforskning.
I det følgende årti kunne den danske forskning gradvist måle sig med de etablerede internationale forskningsgruppers niveau, ikke mindst efter etableringen af teknikken til in vitro-dyrkning af P. falciparum-parasitter [10] (Figur 1).
I begyndelsen var den danske indsats centreret om lægemiddelresistens og identificering af mulige vaccinekandidater. I den første danske malariaartikel af international betydning fra 1979 dokumenterede man for første gang at chloroquinresistent malaria havde spredt sig fra Sydøstasien til Afrika [11]. Artiklen blev fulgt op af flere studier, hvor man underbyggede det oprindelige fund, og senere initieredes et randomiseret prospektivt profylaksestudie blandt danske rejsende [12]. I løbet af 1980’erne og 1990’erne blev forskningsfeltet bredere og omfattede blandt andet forskning i nye lægemidler mod malaria [13]. Der publiceredes stadig flere immunologisk orienterede arbejder om antistof- og cellemedierede reaktioner på forskellige parasitantigener og disses mulige anvendelse i en vaccine. I disse studier udnyttede man i stigende omfang samarbejdet med kolleger i malariaendemiske områder i Afrika, hovedsageligt støttet af Danida. Interessen for parasitantigener udsprang af studier fra 1960’erne, der blev gentaget i 1990’erne, hvor man påviste, at antistoffer er af afgørende betydning for naturligt erhvervet beskyttende immunitet mod malaria [14, 15]. Fra midten af 1980’erne tydede studieresultater på vigtigheden af såkaldte variante antigener for beskyttelse [16], mens resultaterne af andre kohortestudier tydede på, at antistoffer mod højt konserverede regioner af blodstadieantigener var relateret til beskyttelse mod sygdom [17].
En del af dansk malariaforskning blev i løbet af 1990’erne stadig mere fokuseret på variantantigener, mens en anden gruppering forfulgte en vaccineudvikling baseret på konserverede blodstadieantigener. Ved at kombinere dyrkning af malariaparasitter in vitro og samarbejde med afrikanske kolleger med avancerede laboratorieteknikker leverede danske malariaforskere væsentlige bidrag [18] til forståelsen af de variante antigeners betydning for placental malaria [19]. Placental malaria skyldes ophobning af malariainficerede erytrocytter i moderkagen og er en vigtig årsag til sygelighed og dødelighed hos afrikanske førstegangsgravide og deres børn. Det var et afgørende gennembrud
i forståelsen af placental malaria, da danske malariaforskere som de første kunne vise, at ét bestemt parasitprotein, VAR2CSA, er helt afgørende for både patogenese og erhvervet immunitet [20]. Verdens første vaccine, der er designet til specifikt at beskytte unge kvinder mod placental malaria, bliver i øjeblikket klinisk afprøvet flere steder i Europa og Afrika. Resultatet af forskningen i de variante antigener har samtidig medført helt nye perspektiver for diagnose og behandling af kræft [21].
Sideløbende blev der arbejdet med en vaccineudvikling baseret på konserverede antigener. Talrige epidemiologiske studier i Afrika og et enkelt i Myanmar
tydede på vigtigheden af høje antistoftitre mod to malariaantigener for beskyttelse mod sygdom. Disse vaccinekandidater blev hver især afprøvet i succesrige fase 1-forsøg i Europa og Afrika og senere som et fusionsprotein kaldet GMZ2. Fase 1-forsøgene med GMZ2 i Europa og Afrika viste, at antistofferne fra vaccinerede individer var i stand til at hæmme malariaparasitten in vitro [22]. Det første resultat af et stort randomiseret, dobbeltblindet, multicenter, fase 2-forsøg med knap 2.000 børn i fire afrikanske lande er netop blevet offentliggjort [23]. I den anvendte formulering med aluminiumhydroxyd som adjuvans tåles vaccinen godt, men beskyttelsen er for lav. Der er imidlertid mange
lovende delresultater, som vil være af stor værdi i den videre udvikling af næste generations vacciner. Der arbejdes nu på en kombinationsvaccine, som dels giver nogen individbeskyttelse og dels blokerer for malariaparasittens udvikling i myggen.
Herudover har undersøgelser af den molekylære baggrund for alvorlig malaria hos småbørn frembragt lovende resultater [24, 25], der giver håb om forestående gennembrud i forebyggelse og behandling af de mest alvorlige malariakomplikationer hos semiimmune afrikanske småbørn og ikkeimmune personer.
DANSK MALARIAFORSKNING I TAL
Fra den spæde begyndelse i 1970’erne, hvor der var mindre end en håndfuld aktive forskere, er dansk malariaforskning vokset til i dag at omfatte ca. 70 personer. Langt hovedparten er nu tilknyttet Center for Medicinsk Parasitologi, der er et tværinstitutionelt samarbejde mellem Københavns Universitet, Rigshospitalet og Statens Serum Institut. Forskningsfeltet er bredt og omfatter klinisk, epidemiologisk og basal forskning.
I den patientorienterede forskning indgår danske malariapatienter, men fokus er i langt højere grad på både raske og syge mennesker i lande, hvor smitte med malariaparasitter forekommer, særligt i Afrika. Danske malariaforskere er stærkt engagerede i forskningssamarbejder med kolleger i en lang række lande på alle kontinenter. Dansk malariaforskning har resulteret i over 700 videnskabelige publikationer siden 1980 (Figur 2). Udviklingen har været positiv, både i kvantitet og kvalitet, og forskningen publiceres regelmæssigt i førende tidsskrifter. Der er gennem årene desuden tildelt ca. 60 ph.d.-grader fra Københavns Universitet som direkte resultat af denne forskning. Også her har antallet været stigende gennem årene (Figur 2). Hertil skal lægges et antal m.phil.- og ph.d.-grader, der fra udenlandske – især afrikanske – universiteter er tildelt på grund af forskning udført i samarbejde med danske malariaforskere.

Det er værd at bemærke, at forskningsaktiviteterne altovervejende er blevet udført ved hjælp af eksterne midler, det vil sige bevillinger fra danske såvel som udenlandske offentlige og private institutioner og fonde. Herhjemme har særligt Danida, Novo Nordisk Fonden, Det Frie Forskningsråd og Lundbeckfonden ydet betydelige bidrag. Internationalt er forskningen blandt andet støttet af EU, det amerikanske National Institutes of Health og Bill and Melinda Gates Foundation. Med den stærke institutionelle forankring og de solide forskningsresultater beløber den samlede fondsstøtte sig årligt til et tocifret millionbeløb.
INTERNATIONALE RELATIONER
Dansk malariaforskning har fra starten i høj grad været baseret på Danidastøtte til forskeruddannelse og kapacitetsopbygning i de afrikanske samarbejdslande. Denne støtte skete i 1990’erne især i form af det internationalt meget positivt bedømte Enhancement of Research Capacity-program. Dette er sidenhen erstattet af Building Stronger Universities in Developing Countries-programmet [26]. Som en naturlig konsekvens af interessen for en tropisk sygdom har der i alle årene været et bredt internationalt engagement i malariakonsortier og forskningsgrupper, ligesom flere forskere har deltaget flittigt i internationalt malariasamarbejde via poster i råd og komiteer både nationalt, i EU- og i WHO-regi.
FREMTIDEN
Hvordan ser fremtiden så ud? Er vi tættere på at have fundet en effektiv malariavaccine eller få udryddet malaria? Både ja og nej. Antallet af rapporterede malariatilfælde er faldet betydeligt i de senere år [1], selvom tallene er usikre, og der er stor geografisk variation [27]. Under alle omstændigheder dør der stadig hvert år i størrelsesordenen en halv million mennesker af malaria – især små børn og gravide kvinder i Afrika. Til dette helt uacceptabelt høje tal skal lægges det mange gange højere antal mennesker, der hvert år bliver syge af malaria. Konsekvensen er store menneskelige lidelser og massive økonomiske tab, der hver for sig bidrager til den meget skæve velstandsfordeling, der giver store problemer i disse år. Forskning er et vigtigt element i arbejdet med at afhjælpe disse problemer. Danske malariaforskere bidrager både med basal viden og gennem udvikling af nye lovende vacciner mod malaria, hvoraf en er i præklinisk og to i klinisk afprøvning. Det faktum, at ikke færre end seks professorer ved Københavns Universitet har malaria som deres arbejdsområde, er et vigtigt udtryk for, at malariaforskning prioriteters højt i Danmark.
Korrespondance: Micha Phill Grønholm Jepsen.
E-mail: micha@underhavet.dk
Antaget: 16. marts 2017
Interessekonflikter: ingen.
<h2>Litteratur</h2>
<ol type="d">
<li><p>World Malaria Report 2015. WHO, 2015 www.who.int/malaria/publications/world-malaria-report-2015/report/en/ (22. okt 2016).</p></li>
<li><p>Snow RW, Kibuchi E, Karuri SW et al. Changing malaria prevalence on the Kenyan coast since 1974: climate, drugs and vector control. PLoS One 2015;10:e0128792.</p></li>
<li><p>Murray CJL, Rosenfeld LC, Lim SS et al. Global malaria mortality between 1980 and 2010: a systematic analysis. Lancet 2012;379:413-31.</p></li>
<li><p>Global Technical Strategy for Malaria 2016-2030. WHO, 2015.</p></li>
<li><p>RTS,S Clinical Trials Partnership. Efficacy and safety of RTS,S/AS01 malaria vaccine with or without a booster dose in infants and children in Africa: final results of a phase 3, individually randomised, controlled trial. Lancet 2015;386:31-45.</p></li>
<li><p>First malaria vaccine receives positive scientific opinion from EMA. <br>European Medicines Agency, 2015 www.ema.europa.eu/ema/index.jsp?curl=pages/news_and_events/news/2015/07… (22. okt 2016).</p></li>
<li><p>Neafsey DE, Juraska M, Bedford T et al. Genetic diversity and protective efficacy of the RTS,S/AS01 malaria vaccine. N Engl J Med 2015;<br>373:2025-37.</p></li>
<li><p>Olotu A, Fegan G, Wambua J et al. Seven-year efficacy of RTS,S/AS01 malaria vaccine among young African children. New Engl J Med 2016;374:2519-29.</p></li>
<li><p>Statens Serum Institut. Malaria 2015. EPINYT nr. 26, 2016.</p></li>
<li><p>Jepsen S, Andersen BJ. Immunoadsorbent isolation of antigens from the culture medium of in vitro cultivated Plasmodium falciparum. Acta Pathol Microbiol Scan C 1981;89:99-103.</p></li>
<li><p>Fogh S, Jepsen S, Mataya RH. R-III chloroquine-resistant Plasmodium falciparum malaria from northern Malawi. Trans R Soc Trop Med Hyg 1984;78:282.</p></li>
<li><p>Fogh S, Schapira A, Bygbjerg IC et al. Malaria chemoprophylaxis in travellers to east Africa: a comparative prospective study of chloroquine plus proguanil with chloroquine plus sulfadoxine-pyrimethamine. BMJ 1988;296:820-2.</p></li>
<li><p>Chen M, Theander TG, Christensen SB et al. Licochalcone A, a new <br>antimalarial agent, inhibits in vitro growth of the human malaria parasite Plasmodium falciparum and protects mice from P. yoelii infection. <br>Antimicrob Agents Chemother 1994;38:1470-5.</p></li>
<li><p>Cohen S, McGregor IA, Carrington S. Gamma-globulin and acquired immunity to human malaria. Nature 1961;192:733-7. </p></li>
<li><p>Sabchareon A, Burnouf T, Ouattara D et al. Parasitologic and clinical human response to immunoglobulin administration in falciparum malaria. Am J Trop Med Hyg 1991;45:297-308.</p></li>
<li><p>Marsh K, Howard RJ. Antigens induced on erythrocytes by P. falciparum: expression of diverse and conserved determinants. Science 1986;231:150-3.</p></li>
<li><p>Dziegiel M, Rowe P, Bennett S et al. Immunoglobulin M and G antibody responses to Plasmodium falciparum glutamate-rich protein: correlation with clinical immunity in Gambian children. Infect Immun 1993;<br>61:103-8.</p></li>
<li><p>Giha HA, Staalsoe T, Dodoo D et al. Nine-year longitudinal study of antibodies to variant antigens on the surface of Plasmodium falciparum-infected erythrocytes. Infect Immun 1999;67:4092-8.</p></li>
<li><p>Staalsoe T, Shulman CE, Bulmer JN et al. Variant surface antigen-specific IgG and protection against clinical consequences of pregnancy-associated Plasmodium falciparum malaria. Lancet 2004;363:283-9.</p></li>
<li><p>Salanti A, Dahlback M, Turner L et al. Evidence for the involvement of VAR2CSA in pregnancy-associated malaria. J Exp Med 2004;200:1197-203.</p></li>
<li><p>Salanti A, Clausen TM, Agerbaek MO et al. Targeting human cancer by a glycosaminoglycan binding malaria protein. Cancer Cell 2015;28:500-14.</p></li>
<li><p>Jepsen MP, Jogdand PS, Singh SK et al. The malaria vaccine candidate GMZ2 elicits functional antibodies in individuals from malaria endemic and non-endemic areas. J Infect Dis 2013;208:479-88.</p></li>
<li><p>Sirima SB, Mordmuller B, Milligan P et al. A phase 2b randomized, controlled trial of the efficacy of the GMZ2 malaria vaccine in African children. Vaccine 2016;34:4536-42.</p></li>
<li><p>Turner L, Lavstsen T, Berger SS et al. Severe malaria is associated with parasite binding to endothelial protein C receptor. Nature 2013;498:<br>502-5.</p></li>
<li><p>Jensen AT, Magistrado P, Sharp S et al. Plasmodium falciparum associated with severe childhood malaria preferentially expresses PfEMP1 encoded by group A var genes. J Exp Med 2004;199:1179-90.</p></li>
<li><p>Building Stronger Universities in Developing Countries (BSU). <br>www.dkuni.dk/Internationalt/Udviklingslande (30. sep 2016).</p></li>
<li><p>Assele V, Ndoh GE, Nkoghe D et al. No evidence of decline in malaria burden from 2006 to 2013 in a rural Province of Gabon: implications for public health policy. BMC Public Health 2015;15:1-8.</p></li>
</ol>
Malaria – and particularly the disease caused by Plasmodium falciparum – remains a direct as well as indirect cause of poverty and immense human suffering. Research is imperative to alleviate this situation and to control and eventually eradicate the disease. Since the mid-1970s, Danish scientists have contributed increasingly to this effort by publishing more than 700 scientific papers and by training about 60 highly skilled malaria researchers. The efforts which continue to be thoroughly dependent on extensive external funding and public goodwill are briefly reviewed in this article.